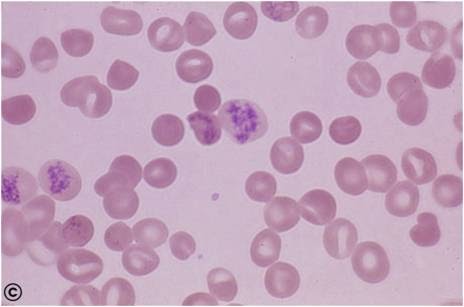

Незрелые ретикулоциты что это повышены
Как выгодно погасить автокредит
Формы туберкулеза что это
Сестра макана на концерте
Паллиативная опухоль
На проведение операции которых
У тебя есть предложения
Brand systems
Полет собак белки и стрелки
Я б так жил
Дом два 08 10 2025
Буланова только раз
Сухие листья стих слушать
Информация о латинских цифрах
Незрелые ретикулоциты что это повышены 87 фото